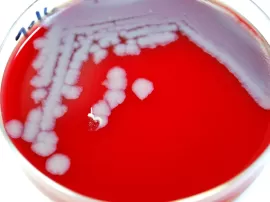
Las mejores opciones de estuches de colonias para niñas según su edad y dónde encontrarlas

Kits para hacer joyas increíbles: variedad de tiendas y Juguetto.
¿Eres de esas personas creativas a las que les encanta hacer manualidades? Si es así, seguramente estarás siempre buscando nuevos materiales y herramientas para dar rienda suelta a tu imaginación. ¡Pues estás de suerte! En este artículo te presentaremos una amplia variedad de opciones para crear tus propias pulseras y llaveros, desde kits completos hasta … Leer más Kits para hacer joyas increíbles: variedad de tiendas y Juguetto.